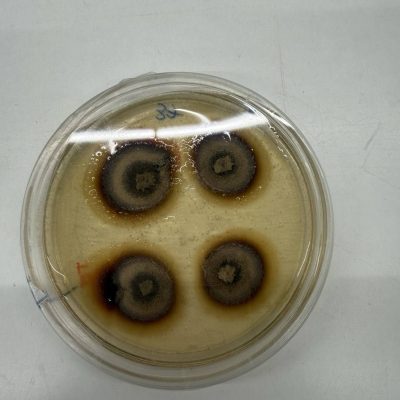
16
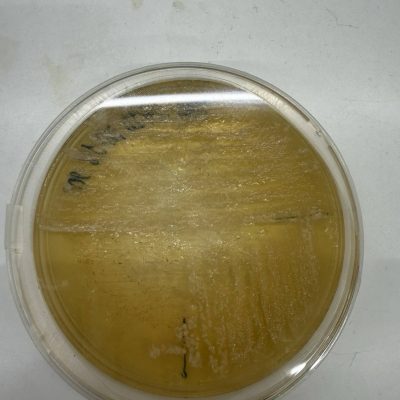
15

Μια πρώτη γνωριμία με τον κόσμο της επιστήμης
Επιστήμη
Published
17 Μαρτίου 2026
Στο πλαίσιο των δράσεων επαγγελματικού προσανατολισμού, οι μαθητές της Γ’ Γυμνασίου επισκέφθηκαν το Εθνικό και Καποδιστριακό Πανεπιστήμιο Αθηνών και το Τμήμα Βιολογίας ΕΚΠΑ, αποκτώντας μια ξεχωριστή εμπειρία μέσα στον χώρο της πανεπιστημιακής εκπαίδευσης και της επιστημονικής έρευνας.
Οι μαθητές είχαν την ευκαιρία να γνωρίσουν το αντικείμενο της Βιολογίας, να ενημερωθούν για τις σύγχρονες επιστημονικές εξελίξεις και να κατανοήσουν τον σημαντικό ρόλο που διαδραματίζει η επιστήμη στη μελέτη της ζωής, της υγείας και του περιβάλλοντος. Παράλληλα, μέσα από την άμεση επαφή με το πανεπιστημιακό περιβάλλον, ήρθαν πιο κοντά στις σπουδές και στις επαγγελματικές προοπτικές που ανοίγονται στον χώρο των βιοεπιστημών.
Τέτοιες εμπειρίες αποτελούν πολύτιμο ερέθισμα για τους μαθητές, καθώς τους βοηθούν να διευρύνουν τους ορίζοντές τους και να σκεφτούν πιο συνειδητά τις μελλοντικές ακαδημαϊκές και επαγγελματικές επιλογές τους.
ΕτικετοποιημένοΕπαγγελματικός Προσανατολισμός